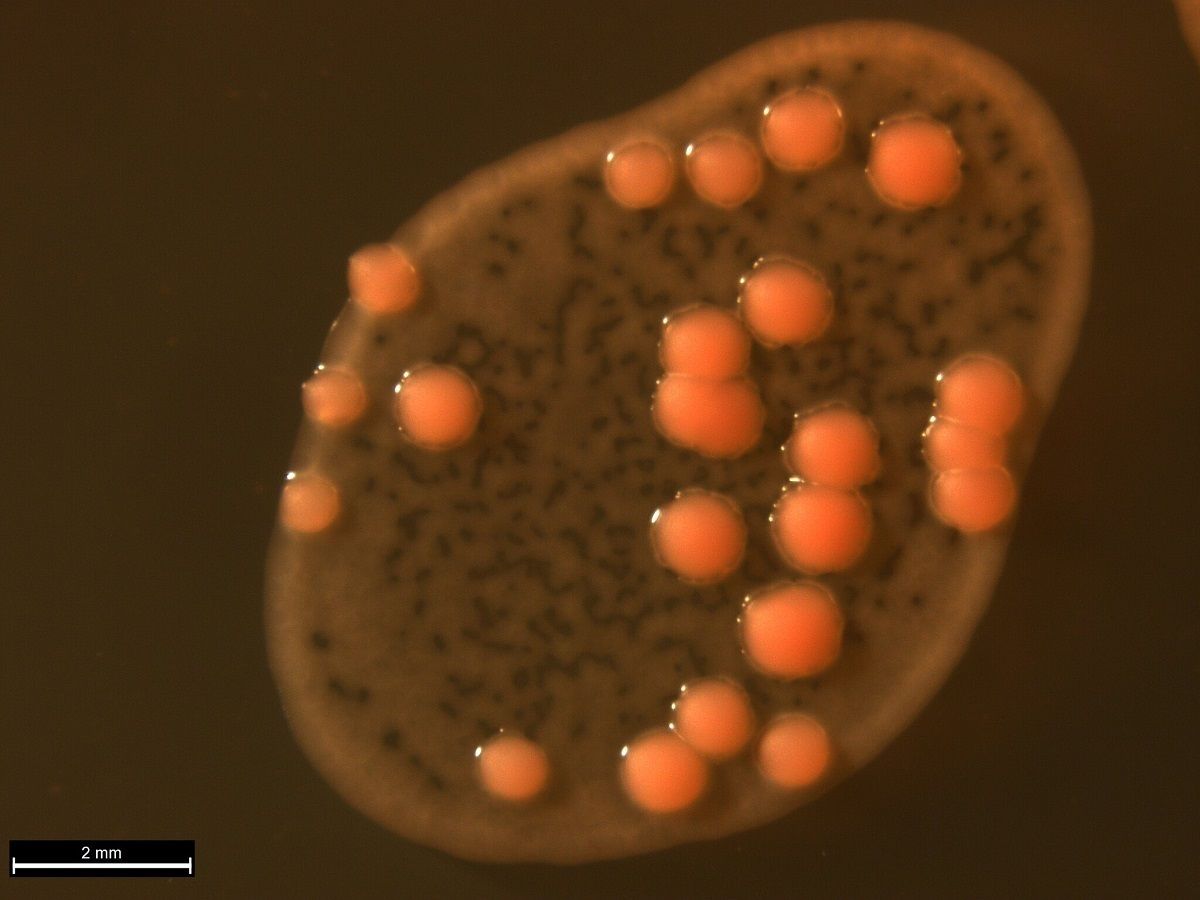

Ученые из Петербурга нашли вызывающий заболевания симбиоз инфузории и дрожжей
Ученые Санкт-Петербургского государственного университета первыми в мире нашли и подробно описали симбиоз инфузории и дрожжей из водной среды.
Заражение дрожжами инфузорий способствует распространению грибковых заболеваний у людей, сообщили в пресс-службе вуза.
«Биологам в данном случае удалось выделить из природного водоема клон инфузорий, несущий в цитоплазме дрожжи. Таким образом, они первыми в мире нашли и подробно описали симбиоз инфузории и дрожжей из водной среды», – говорится в сообщении.
Симбиозы – это совместное существование неродственных организмов, которое может нести как пользу, так и вред. Инфузории часто формируют ассоциации с другими микроорганизмами, что играет важную роль в экологии водоемов и представляет интерес для ученых. Также недавно науке стало известно, что к числу симбионтов инфузорий могут относиться микроорганизмы, вызывающие заболевания человека, или родственные им.
С помощью современных методов исследований ученые охарактеризовали симбиотическую систему и продемонстрировали, что симбионты инфузории этого клона имеют строение, типичное для дрожжей. Они определили последовательности маркерных генов инфузории и дрожжей, видовую принадлежность партнеров. Также биологи провели экспериментальное заражение и показали, что инфузории Paramecium bursaria заражаются дрожжами Rhodotorula mucilaginosa, если в среде их концентрация повышена. 40 лет назад эти дрожжи считались безвредными, сейчас же ученые определили, что эти организмы могут вызывать у людей грибковые инфекции. Это подтверждает гипотезу о том, что инфузории могут быть переносчиками возбудителей некоторых болезней человека.
«Мы показали, что инфузории Paramecium bursaria способны спонтанно заражаться дрожжами Rhodotorula mucilaginosa в природе. Эта способность характерна не только для лабораторной культуры, которая может быть ослаблена из-за длительного содержания в искусственных условиях и экспериментов», – привели в пресс-службе слова доцента кафедры цитологии и гистологии СПбГУ Елены Сабанеевой.
Ранее петербургские ученые разработали цифрового помощника для автоматизации химических исследований.